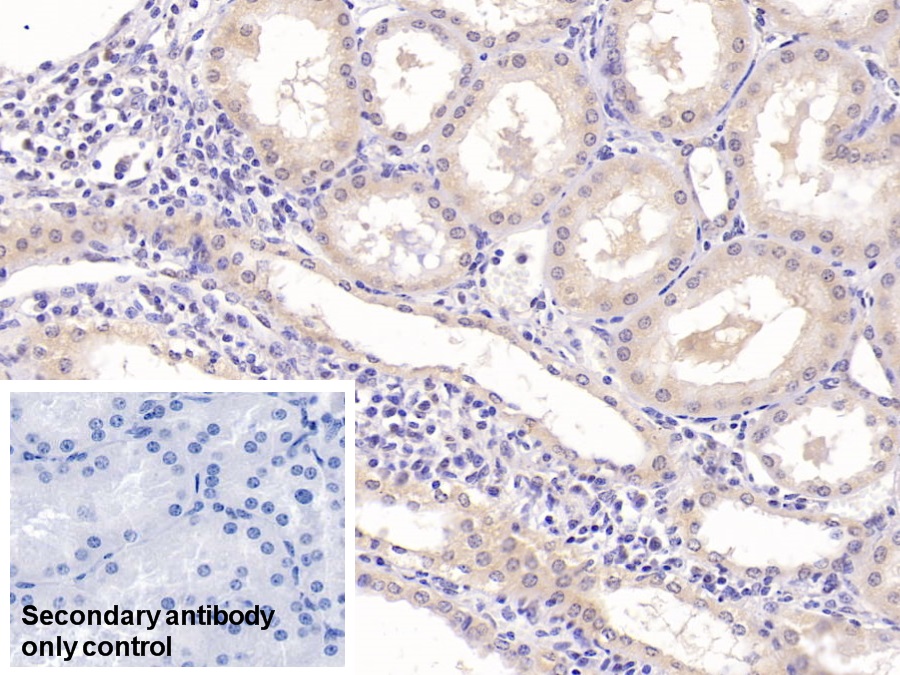

Monoclonal Antibody to Epidermal Growth Factor (EGF) 

URG; Beta-Urogastrone; Pro-epidermal growth factor
Overview
Properties
- Product No.MAA560Hu21
- Organism SpeciesHomo sapiens (Human) Same name, Different species.
- ApplicationsWB; IHC
If the antibody is used in flow cytometry, please check FCM antibodies.
Research use only - DownloadInstruction Manual
- CategoryCytokineTumor immunityInfection immunity
- SourceMonoclonal antibody preparation, Host Mouse
- Ig Isotype IgG2b Kappa, Clone Number D2
- PurificationProtein A + Protein G affinity chromatography
- LabelNone
- Immunogen RPA560Hu02-Recombinant Epidermal Growth Factor (EGF)
- Buffer Formulation0.01M PBS, pH7.4, containing 0.05% Proclin-300, 50% glycerol.
- TraitsLiquid, Concentration 1mg/mL
Sign into your account
Share a new citation as an author
Upload your experimental result
Review

Contact us
Please fill in the blank.
Specifity
The antibody is a mouse monoclonal antibody raised against EGF. It has been selected for its ability to recognize EGF in immunohistochemical staining and western blotting.
Usage
Western blotting: 0.01-2µg/mL;
Immunohistochemistry: 5-20µg/mL;
Immunocytochemistry: 5-20µg/mL;
Optimal working dilutions must be determined by end user.
Storage
Store at 4°C for frequent use. Stored at -20°C in a manual defrost freezer for two year without detectable loss of activity. Avoid repeated freeze-thaw cycles.
Stability
The thermal stability is described by the loss rate. The loss rate was determined by accelerated thermal degradation test, that is, incubate the protein at 37°C for 48h, and no obvious degradation and precipitation were observed. The loss rate is less than 5% within the expiration date under appropriate storage condition.
Giveaways
Increment services
-
 Antibody Labeling Customized Service
Antibody Labeling Customized Service
-
 Protein A/G Purification Column
Protein A/G Purification Column
-
 Staining Solution for Cells and Tissue
Staining Solution for Cells and Tissue
-
 Positive Control for Antibody
Positive Control for Antibody
-
 Tissue/Sections Customized Service
Tissue/Sections Customized Service
-
 Phosphorylated Antibody Customized Service
Phosphorylated Antibody Customized Service
-
 Western Blot (WB) Experiment Service
Western Blot (WB) Experiment Service
-
 Immunohistochemistry (IHC) Experiment Service
Immunohistochemistry (IHC) Experiment Service
-
 Immunocytochemistry (ICC) Experiment Service
Immunocytochemistry (ICC) Experiment Service
-
 Flow Cytometry (FCM) Experiment Service
Flow Cytometry (FCM) Experiment Service
-
 Immunoprecipitation (IP) Experiment Service
Immunoprecipitation (IP) Experiment Service
-
 Immunofluorescence (IF) Experiment Service
Immunofluorescence (IF) Experiment Service
-
 Buffer
Buffer
-
 DAB Chromogen Kit
DAB Chromogen Kit
-
 SABC Kit
SABC Kit
-
 Long-arm Biotin Labeling Kit
Long-arm Biotin Labeling Kit
-
 Real Time PCR Experimental Service
Real Time PCR Experimental Service
Citations
- The influence of nutrients, biliary-pancreatic secretions, and systemic trophic hormones on intestinal adaptation in a Roux-en-Y bypass modelPubMed: 20438940
- Decreased Epidermal Growth Factor (EGF) Associated with HMGB1 and Increased Hyperactivity in Children with AutismPubMed: PMC3623607
- The Probiotic Mixture VSL#3 Accelerates Gastric Ulcer Healing by Stimulating Vascular Endothelial Growth FactorPubMed: PMC3590171
- Allogeneic transplantation of an adipose-derived stem cell (ASC) sheet combined with artificial skin accelerates wound healing in a rat wound model of type 2 diabetes and obesityPubmed:25795216
- Association of colon adenomas and skin tags: coincidence or coexistence?Pubmed:24763889
- The effects of self-assembling peptide RADA16 hydrogel on malignant phenotype of human hepatocellular carcinoma cellPubMed: 26628972
- Polydopamine nanoparticles modulating stimuli-responsive PNIPAM hydrogels with cell/tissue adhesiveness.pubmed:27709887
- The effect of midkine on growth factors and oxidative status in an experimental wound model in diabetic and healthy ratspubmed:28177680
- A DPP-IV-resistant glucagon-like peptide-2 dimer with enhanced activity against radiation-induced intestinal injurypubmed:28522195
- Optimization of Storage Temperature for Retention of Undifferentiated Cell Character of Cultured Human Epidermal Cell Sheetspubmed:28811665
- Micro-/nano-topography of selective laser melting titanium enhances adhesion and proliferation and regulates adhesion-related gene expressions of human …Pubmed: 30233172
- Patient-derived xenograft (PDX) models of colorectal carcinoma (CRC) as a platform for chemosensitivity and biomarker analysis in personalized medicinePubmed: 33212364
- Adipose-Derived Stem Cells Improve the Aging Skin of Nude Mice by Promoting Angiogenesis and Reducing Local Tissue Water33428732
- Sodium/glucose cotransporter 1-dependent metabolic alterations induce tamoxifen resistance in breast cancer by promoting macrophage M2 polarization34006822
- The Paracrine Effect of Adipose-Derived Stem Cells Orchestrates Competition between Different Damaged Dermal Fibroblasts to Repair UVB-Induced Skin?¡33381190
- Umbilical cord-derived mesenchymal stem cell conditioned medium reverses neuronal oxidative injury by inhibition of TRPM2 activation and the JNK signaling …Pubmed:35585377
- Human adipose-derived stem cell-loaded small intestinal submucosa as a bioactive wound dressing for the treatment of diabetic wounds in rats
- Syringaresinol attenuates kidney injury by inhibition of pyroptosis via activating the Nrf2 antioxidant pathway in diabetic nephropathy
- Beetroot Improves the Therapeutic Efficacy of Bone Marrow-Derived Mesenchymal Stem Cells in Preventing Cisplatin Induced Nephrotoxicity in Male Rats